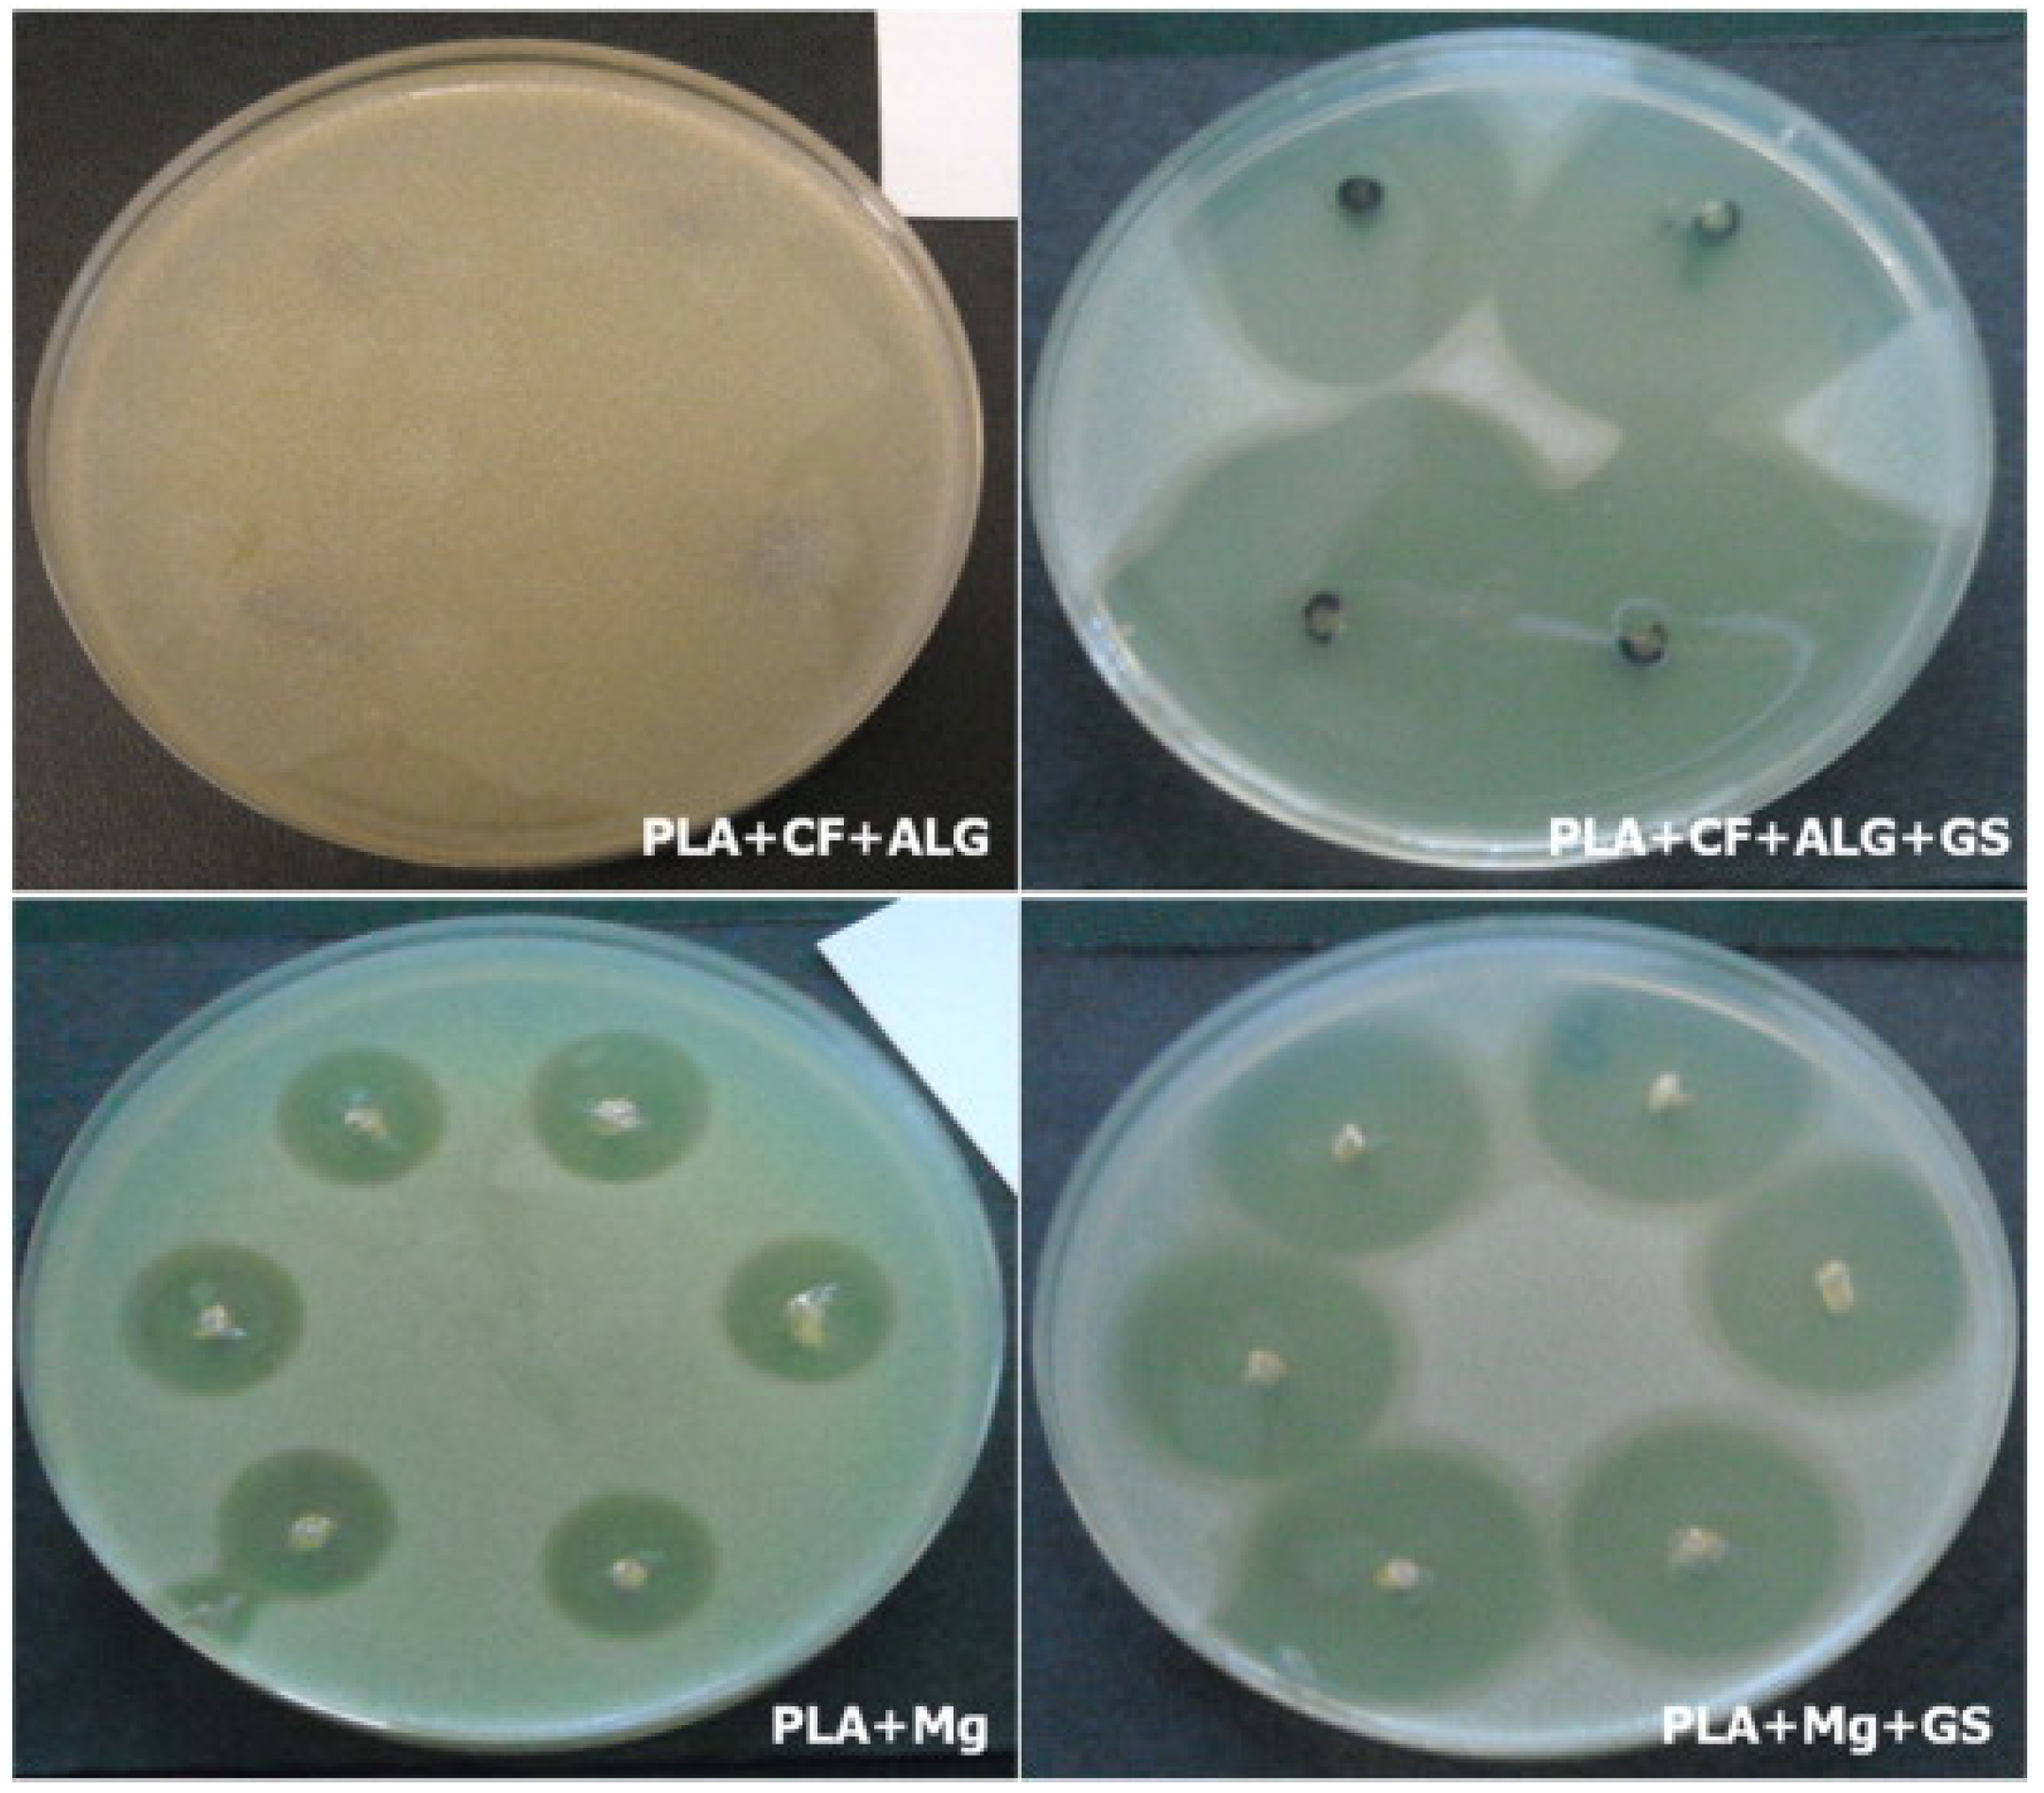
Coatings 11 01006 g018

Review on Surface Treatment for Implant Infection via Gentamicin and Antibiotic Releasing Coatings
Abstract
1. Introduction
2. Pathology of Infection
2.1. Etiology of Infection
2.2. Microorganism
2.3. Mechanism of Biofilm
3. Antibiotics and Antibiotic Imitated Coatings
4. Mechanical Properties and Characterization of Gentamicin and Its Composites
5. Microbial Assay
6. Clinical Studies
7. Conclusions
Author Contributions
Funding
Institutional Review Board Statement
Informed Consent Statement
Data Availability Statement
Acknowledgments
Conflicts of Interest
References
- Office of the Surgeon General (US). Bone Health and Osteoporosis: A Report of the Surgeon General. Rockville (MD): Office of the Surgeon General (US); The Basics of Bone in Health and Disease. 2004; Volume 2. Available online: https://www.ncbi.nlm.nih.gov/books/NBK45504/ (accessed on 3 August 2021).
- Berry, S.D.; Miller, R.R. Falls: Epidemiology, pathophysiology, and relationship to fracture. Curr. Osteoporos. Rep. 2008, 6, 149–154. [Google Scholar] [CrossRef]
- White, T.D.; Black, M.T.; Folkens, P.A. Chapter 1—Introduction. In Human Osteology, 3rd ed.; White, T.D., Black, M.T., Folkens, P.A., Eds.; Academic Press: San Diego, CA, USA, 2012; pp. 1–9. [Google Scholar] [CrossRef]
- Gunn, C. Bones and Joints-E-Book: A Guide for Students, 6th ed.; Elsevier Health Sciences: Philadelphia, PA, USA, 2011. [Google Scholar]
- Sahoo, N.; Anand, S.; Bhardwaj, J.; Sachdeva, V.; Sapru, B. Bone response to stainless steel and titanium bone plates: An experimental study on animals. Med. J. Armed Forces India 1994, 50, 10–14. [Google Scholar] [CrossRef]
- Anderson, J.M.; Rodriguez, A.; Chang, D.T. Foreign body reaction to biomaterials. Semin. Immunol. 2008, 20, 86–100. [Google Scholar] [CrossRef]
- Crincoli, V.; Cazzolla, A.P.; Di Comite, M.; Lo Muzio, L.; Ciavarella, D.; Dioguardi, M.; Bizzoca, M.E.; Palmieri, G.; Fontana, A.; Giustino, A.; et al. Evaluation of Vitamin D (25OHD), Bone Alkaline Phosphatase (BALP), Serum Calcium, Serum Phosphorus, Ionized Calcium in Patients with Mandibular Third Molar Impaction. An Observational Study. Nutrients 2021, 13, 1938. [Google Scholar] [CrossRef]
- Berdal, A.; Bailleul-Forestier, I.B.I.; Davideau, J.-L.; LÉZot, F. CHAPTER 34 - Dento-alveolar Bone Complex and Vitamin D. In Vitamin D, 2nd ed.; Feldman, D., Ed.; Academic Press: Burlington, NJ, USA, 2005; pp. 599–607. [Google Scholar] [CrossRef]
- Gallo, J.; Holinka, M.; Moucha, C.S. Antibacterial surface treatment for orthopaedic implants. Int. J. Mol. Sci. 2014, 15, 13849–13880. [Google Scholar] [CrossRef] [PubMed]
- Saravanan, A. Antibiotic Cement Impregnated Nailing in the Management of Infected Non Union of Femur and Tibia: A Prospective Study; Kilpauk Medical College: Chennai, India, 2010. [Google Scholar]
- Veerachamy, S.; Yarlagadda, T.; Manivasagam, G.; Yarlagadda, P.K. Bacterial adherence and biofilm formation on medical implants: A review. Proc. Inst. Mech. Eng. Part H J. Eng. Med. 2014, 228, 1083–1099. [Google Scholar] [CrossRef]
- Horan, T.C.; Gaynes, R.P.; Martone, W.J.; Jarvis, W.R.; Grace Emori, T. CDC definitions of nosocomial surgical site infections, 1992: A modification of CDC definitions of surgical wound infections. Am. J. Infect. Control 1992, 20, 271–274. [Google Scholar] [CrossRef]
- Lakdawala, M.; Hassan, P.; Kothwala, D.; Malik, G. Poly (D, L-Lactide)-Gentamicin composite coated orthopaedic metallic implant. Int. J. Sci. Nat. 2013, 4, 522–529. [Google Scholar]
- Zaborowska, M.; Welch, K.; Brånemark, R.; Khalilpour, P.; Engqvist, H.; Thomsen, P.; Trobos, M. Bacteria-material surface interactions: Methodological development for the assessment of implant surface induced antibacterial effects. J. Biomed. Mater. Res. Part B Appl. Biomater. 2015, 103, 179–187. [Google Scholar] [CrossRef]
- Krause, K.M.; Serio, A.W.; Kane, T.R.; Connolly, L.E. Aminoglycosides: An Overview. Cold Spring Harb. Perspect. Med. 2016, 6, a027029. [Google Scholar] [CrossRef] [PubMed]
- Gonzalez, L.S., 3rd; Spencer, J.P. Aminoglycosides: A practical review. Am. Fam. Physician 1998, 58, 1811–1820. [Google Scholar]
- Tamma, P.D.; Cosgrove, S.E.; Maragakis, L.L. Combination therapy for treatment of infections with gram-negative bacteria. Clin. Microbiol. Rev. 2012, 25, 450–470. [Google Scholar] [CrossRef]
- Chen, C.; Chen, Y.; Wu, P.; Chen, B. Update on new medicinal applications of gentamicin: Evidence-based review. J. Formos. Med Assoc. Taiwan Yi Zhi 2014, 113, 72–82. [Google Scholar] [CrossRef]
- Diana, G.; Margarida, P.; Ana Francisca, B. Osteomyelitis: An overview of antimicrobial therapy. Braz. J. Pharm. Sci. 2013, 49, 13–27. [Google Scholar]
- Wen, Y.; Xu, J. Scientific Importance of Water-Processable PEDOT–PSS and Preparation, Challenge and New Application in Sensors of Its Film Electrode: A Review. J. Polym. Sci. Part A Polym. Chem. 2017, 55, 1121–1150. [Google Scholar] [CrossRef]
- Birt, M.C.; Anderson, D.W.; Toby, E.B.; Wang, J. Osteomyelitis: Recent advances in pathophysiology and therapeutic strategies. J. Orthop. 2017, 14, 45–52. [Google Scholar] [CrossRef] [PubMed]
- Andriole, V.T.; Nagel, D.A.; Southwick, W. Chronic staphylococcal osteomyelitis: An experimental model. Yale J. Biol. Med. 1974, 47, 33. [Google Scholar]
- Orapiriyakul, W.; Young, P.S.; Damiati, L. Antibacterial surface modification of titanium implants in orthopaedics. J. Tissue Eng. 2018, 9, 2041731418789838. [Google Scholar] [CrossRef] [PubMed]
- Dickinson, G.M.; Bisno, A.L. Infections associated with indwelling devices: Infections related to extravascular devices. Antimicrob. Agents Chemother. 1989, 33, 602. [Google Scholar] [CrossRef]
- Ostermann, P.A.; Henry, S.L.; Seligson, D. Timing of wound closure in severe compound fractures. Orthopedics 1994, 17, 397–399. [Google Scholar] [CrossRef]
- Lichter, J.A.; Van Vliet, K.J.; Rubner, M.F. Design of Antibacterial Surfaces and Interfaces: Polyelectrolyte Multilayers as a Multifunctional Platform. Macromolecules 2009, 42, 8573–8586. [Google Scholar] [CrossRef]
- Upadhyayula, V.K.; Gadhamshetty, V. Appreciating the role of carbon nanotube composites in preventing biofouling and promoting biofilms on material surfaces in environmental engineering: A review. Biotechnol. Adv. 2010, 28, 802–816. [Google Scholar] [CrossRef]
- Tuson, H.H.; Weibel, D.B. Bacteria-surface interactions. Soft Matter 2013, 9, 4368–4380. [Google Scholar] [CrossRef]
- Hall-Stoodley, L.; Costerton, J.W.; Stoodley, P. Bacterial biofilms: From the natural environment to infectious diseases. Nat. Rev. Microbiol. 2004, 2, 95–108. [Google Scholar] [CrossRef] [PubMed]
- Stoodley, P.; Sauer, K.; Davies, D.G.; Costerton, J.W. Biofilms as complex differentiated communities. Annu. Rev. Microbiol. 2002, 56, 187–209. [Google Scholar] [CrossRef] [PubMed]
- Bernier, S.P.; Silo-Suh, L.; Woods, D.E.; Ohman, D.E.; Sokol, P.A. Comparative analysis of plant and animal models for characterization of Burkholderia cepacia virulence. Infect. Immun. 2003, 71, 5306–5313. [Google Scholar] [CrossRef] [PubMed]
- Costerton, J.W.; Cheng, K.; Geesey, G.G.; Ladd, T.I.; Nickel, J.C.; Dasgupta, M.; Marrie, T.J. Bacterial biofilms in nature and disease. Annu. Rev. Microbiol. 1987, 41, 435–464. [Google Scholar] [CrossRef] [PubMed]
- Costerton, J.W.; Stewart, P.S.; Greenberg, E.P. Bacterial biofilms: A common cause of persistent infections. Science 1999, 284, 1318–1322. [Google Scholar] [CrossRef] [PubMed]
- Kunin, C.M. Blockage of urinary catheters: Role of microorganisms and constituents of the urine on formation of encrustations. J. Clin. Epidemiol. 1989, 42, 835–842. [Google Scholar] [CrossRef]
- Reid, G. Biofilms in infectious disease and on medical devices. Int. J. Antimicrob. Agents 1999, 11, 223–226. [Google Scholar] [CrossRef]
- Santos, A.L.S.d.; Galdino, A.C.M.; Mello, T.P.d.; Ramos, L.d.S.; Branquinha, M.H.; Bolognese, A.M.; Neto, J.C.; Roudbary, M. What are the advantages of living in a community? A microbial biofilm perspective! Memórias Do Inst. Oswaldo Cruz 2018, 113, 1–7. [Google Scholar] [CrossRef] [PubMed]
- Habash, M.; Reid, G. Microbial biofilms: Their development and significance for medical device—related infections. J. Clin. Pharmacol. 1999, 39, 887–898. [Google Scholar] [CrossRef] [PubMed]
- Del Pozo, J.; Patel, R. The challenge of treating biofilm-associated bacterial infections. Clin. Pharmacol. Ther. 2007, 82, 204–209. [Google Scholar] [CrossRef] [PubMed]
- Alhede, M.; Er, Ö.; Eickhardt, S.; Kragh, K.; Alhede, M.; Christensen, L.D.; Poulsen, S.S.; Givskov, M.; Christensen, L.H.; Høiby, N. Bacterial biofilm formation and treatment in soft tissue fillers. Pathog. Dis. 2014, 70, 339–346. [Google Scholar] [CrossRef]
- Garrett, T.R.; Bhakoo, M.; Zhang, Z. Bacterial adhesion and biofilms on surfaces. Prog. Nat. Sci. 2008, 18, 1049–1056. [Google Scholar] [CrossRef]
- Cheng, G.; Li, G.; Xue, H.; Chen, S.; Bryers, J.D.; Jiang, S. Zwitterionic carboxybetaine polymer surfaces and their resistance to long-term biofilm formation. Biomaterials 2009, 30, 5234–5240. [Google Scholar] [CrossRef]
- Roosjen, A.; van der Mei, H.C.; Busscher, H.J.; Norde, W. Microbial adhesion to poly (ethylene oxide) brushes: Influence of polymer chain length and temperature. Langmuir 2004, 20, 10949–10955. [Google Scholar] [CrossRef] [PubMed]
- Schumacher, J.F.; Carman, M.L.; Estes, T.G.; Feinberg, A.W.; Wilson, L.H.; Callow, M.E.; Callow, J.A.; Finlay, J.A.; Brennan, A.B. Engineered antifouling microtopographies–effect of feature size, geometry, and roughness on settlement of zoospores of the green alga Ulva. Biofouling 2007, 23, 55–62. [Google Scholar] [CrossRef] [PubMed]
- LING III, J.F.; GRAHAM, M.V.; CADY, N.C. Effect of topographically patterned poly (dimethylsiloxane) surfaces on pseudomonas aeruginosa adhesion and biofilm formation. Nano Life 2012, 2, 1242004. [Google Scholar] [CrossRef]
- Salick, D.A.; Kretsinger, J.K.; Pochan, D.J.; Schneider, J.P. Inherent antibacterial activity of a peptide-based beta-hairpin hydrogel. J. Am. Chem. Soc. 2007, 129, 14793–14799. [Google Scholar] [CrossRef]
- Laloyaux, X.; Fautré, E.; Blin, T.; Purohit, V.; Leprince, J.; Jouenne, T.; Jonas, A.M.; Glinel, K. Temperature-responsive polymer brushes switching from bactericidal to cell-repellent. Adv. Mater. (Deerfield Beach Fla.) 2010, 22, 5024–5028. [Google Scholar] [CrossRef]
- Shukla, A.; Fleming, K.E.; Chuang, H.F.; Chau, T.M.; Loose, C.R.; Stephanopoulos, G.N.; Hammond, P.T. Controlling the release of peptide antimicrobial agents from surfaces. Biomaterials 2010, 31, 2348–2357. [Google Scholar] [CrossRef] [PubMed]
- Kazemzadeh-Narbat, M.; Lai, B.F.; Ding, C.; Kizhakkedathu, J.N.; Hancock, R.E.; Wang, R. Multilayered coating on titanium for controlled release of antimicrobial peptides for the prevention of implant-associated infections. Biomaterials 2013, 34, 5969–5977. [Google Scholar] [CrossRef] [PubMed]
- Wang, Y.; Jayan, G.; Patwardhan, D.; Phillips, K.S. Antimicrobial and anti-biofilm medical devices: Public health and regulatory science challenges. In Antimicrobial Coatings and Modifications on Medical Devices; Springer: New York, NY, USA, 2017; pp. 37–65. [Google Scholar]
- Raschke, M.J.; Fuchs, T.; Stange, R.; Lucke, M.; Kandziora, F.; Wildemann, B.; Schmidmaier, G. Active Coating of Implants used in Orthopedic Surgery. In Practice of Intramedullary Locked Nails: New Developments in Techniques and Applications; Leung, K.-S., Taglang, G., Schnettler, R., Alt, V., Haarman, H.J.T.M., Seidel, H., Kempf, I., Eds.; Springer: Berlin/Heidelberg, Germany, 2006; pp. 283–296. [Google Scholar] [CrossRef]
- Schmidmaier, G.; Wildemann, B.; Stemberger, A.; Haas, N.; Raschke, M. Biodegradable poly (D, L-lactide) coating of implants for continuous release of growth factors. J. Biomed. Mater. Res. Off. J. Soc. Biomater. Jpn. Soc. Biomater. Aust. Soc. Biomater. Korean Soc. Biomater. 2001, 58, 449–455. [Google Scholar] [CrossRef] [PubMed]
- Qin, S.; Xu, K.; Nie, B.; Ji, F.; Zhang, H. Approaches based on passive and active antibacterial coating on titanium to achieve antibacterial activity. J. Biomed. Mater. Res. Part A 2018, 106, 2531–2539. [Google Scholar] [CrossRef] [PubMed]
- Romanò, C.L.; Scarponi, S.; Gallazzi, E.; Romanò, D.; Drago, L. Antibacterial coating of implants in orthopaedics and trauma: A classification proposal in an evolving panorama. J. Orthop. Surg. Res. 2015, 10, 157. [Google Scholar] [CrossRef] [PubMed]
- Romanò, C.L.; Tsuchiya, H.; Morelli, I.; Battaglia, A.G.; Drago, L. Antibacterial coating of implants: Are we missing something? Bone Jt. Res. 2019, 8, 199–206. [Google Scholar] [CrossRef] [PubMed]
- Strobel, C.; Schmidmaier, G.; Wildemann, B. Changing the release kinetics of gentamicin from poly(D,L-lactide) implant coatings using only one polymer. Int. J. Artif. Organs 2011, 34, 304–316. [Google Scholar] [CrossRef]
- Shi, Z.; Neoh, K.G.; Kang, E.T.; Wang, W. Antibacterial and mechanical properties of bone cement impregnated with chitosan nanoparticles. Biomaterials 2006, 27, 2440–2449. [Google Scholar] [CrossRef]
- Staiger, M.P.; Pietak, A.M.; Huadmai, J.; Dias, G. Magnesium and its alloys as orthopedic biomaterials: A review. Biomaterials 2006, 27, 1728–1734. [Google Scholar] [CrossRef] [PubMed]
- Wen, C.; Mabuchi, M.; Yamada, Y.; Shimojima, K.; Chino, Y.; Asahina, T. Processing of biocompatible porous Ti and Mg. Scr. Mater. 2001, 45, 1147–1153. [Google Scholar] [CrossRef]
- Tencer, A.F.; Johnson, K.D. Biomechanics in Orthopedic Trauma: Bone Fracture and Fixation; Martin Dunitz London: London, UK, 1994; Volume 76, p. 1438. [Google Scholar]
- Settle, F.A. Handbook of Instrumental Techniques for Analytical Chemistry; Prentice Hall PTR: Upper Saddle River, NJ, USA, 1997. [Google Scholar]
- Chalmers, J.M.; Edwards, H.G.; Hargreaves, M.D. Infrared and Raman Spectroscopy in Forensic Science; John Wiley & Sons: New York, NY, USA, 2012. [Google Scholar]
- McCreery, R.L. Raman Spectroscopy for Chemical Analysis; John Wiley & Sons: New York, NY, USA, 2005; Volume 225. [Google Scholar]
- Witkowski, M.R. The use of Raman spectroscopy in the detection of counterfeit and adulterated pharmaceutical products. Am. Pharm. Rev. 2005, 8, 56. [Google Scholar]
- McManamon, C.; Delaney, P.; Kavanagh, C.; Wang, J.J.; Rasappa, S.; Morris, M.A. Depth profiling of PLGA copolymer in a novel biomedical bilayer using confocal Raman spectroscopy. Langmuir 2013, 29, 5905–5910. [Google Scholar] [CrossRef]
- Belu, A.; Mahoney, C.; Wormuth, K. Chemical imaging of drug eluting coatings: Combining surface analysis and confocal Raman microscopy. J. Control. Release 2008, 126, 111–121. [Google Scholar] [CrossRef]
- Nast, S.; Fassbender, M.; Bormann, N.; Beck, S.; Montali, A.; Lucke, M.; Schmidmaier, G.; Wildemann, B. In vivo quantification of gentamicin released from an implant coating. J. Biomater. Appl. 2016, 31, 45–54. [Google Scholar] [CrossRef]
- Li, Q.; He, G. Gelatin-enhanced porous titanium loaded with gentamicin sulphate and in vitro release behavior. Mater. Des. 2016, 99, 459–466. [Google Scholar] [CrossRef]
- Pan, X.; Chen, S.; Li, D.; Rao, W.; Zheng, Y.; Yang, Z.; Li, L.; Guan, X.; Chen, Z. The synergistic antibacterial mechanism of gentamicin-loaded CaCO3 nanoparticles. Front. Chem. 2018, 5, 130. [Google Scholar] [CrossRef] [PubMed]
- Morawska-Chochół, A.; Domalik-Pyzik, P.; Chłopek, J.; Szaraniec, B.; Sterna, J.; Rzewuska, M.; Boguń, M.; Kucharski, R.; Mielczarek, P. Gentamicin release from biodegradable poly-l-lactide based composites for novel intramedullary nails. Mater. Sci. Eng. C 2014, 45, 15–20. [Google Scholar] [CrossRef] [PubMed]
- Vester, H.; Wildemann, B.; Schmidmaier, G.; Stöckle, U.; Lucke, M. Gentamycin delivered from a PDLLA coating of metallic implants: In vivo and in vitro characterisation for local prophylaxis of implant-related osteomyelitis. Injury 2010, 41, 1053–1059. [Google Scholar] [CrossRef] [PubMed]
- Boselli, E.; Allaouchiche, B. Diffusion in bone tissue of antibiotics. Presse Med. 1999, 28, 2265–2276. [Google Scholar]
- Fraimow, H.S. Systemic antimicrobial therapy in osteomyelitis. Semin. Plast. Surg. 2009, 23, 90–99. [Google Scholar] [CrossRef]
- Metsemakers, W.; Reul, M.; Nijs, S. The use of gentamicin-coated nails in complex open tibia fracture and revision cases: A retrospective analysis of a single centre case series and review of the literature. Injury 2015, 46, 2433–2437. [Google Scholar] [CrossRef]
- Thonse, R.; Conway, J. Antibiotic cement-coated interlocking nail for the treatment of infected nonunions and segmental bone defects. J. Orthop. Trauma 2007, 21, 258–268. [Google Scholar] [CrossRef]
- Morawska-Chochół, A.; Domalik-Pyzik, P.; Menaszek, E.; Sterna, J.; Bielecki, W.; Bonecka, J.; Boguń, M.; Chłopek, J. Biodegradable intramedullary nails reinforced with carbon and alginate fibers: In vitro and in vivo biocompatibility. J. Appl. Biomater. Funct. Mater. 2018, 16, 36–41. [Google Scholar] [CrossRef] [PubMed]
- Raj, R.M.; Priya, P.; Raj, V. Gentamicin-loaded ceramic-biopolymer dual layer coatings on the Ti with improved bioactive and corrosion resistance properties for orthopedic applications. J. Mech. Behav. Biomed. Mater. 2018, 82, 299–309. [Google Scholar]
- Saravanan, A.; Ganesh, R.R.; Ismail, N.D.M.; Anandan, H. Antibiotic Cement Impregnated Nailing in Management of Infected Non-union of Femur and Tibia. Int. J. Sci. Study 2017, 5, 187–191. [Google Scholar]
- He, L.-J.; Hao, J.-C.; Dai, L.; Zeng, R.-C.; Li, S.-Q. Layer-by-layer assembly of gentamicin-based antibacterial multilayers on Ti alloy. Mater. Lett. 2020, 261, 127001. [Google Scholar] [CrossRef]
- Bhatia, C.; Tiwari, A.; Sharma, S.; Thalanki, S.; Rai, A. Role of antibiotic cement coated nailing in infected nonunion of tibia. Malays. Orthop. J. 2017, 11, 6. [Google Scholar] [PubMed]
- Vicenti, G.; Bizzoca, D.; Cotugno, D.; Carrozzo, M.; Riefoli, F.; Rifino, F.; Belviso, V.; Elia, R.; Solarino, G.; Moretti, B. The use of a gentamicin-coated titanium nail, combined with RIA system, in the management of non-unions of open tibial fractures: A single centre prospective study. Injury 2019, 51, S86–S91. [Google Scholar] [CrossRef]
- Pinto, D.; Manjunatha, K.; Savur, A.D.; Ahmed, N.R.; Mallya, S.; Ramya, V. Comparative study of the efficacy of gentamicin-coated intramedullary interlocking nail versus regular intramedullary interlocking nail in Gustilo type I and II open tibia fractures. Chin. J. Traumatol. 2019, 22, 270–273. [Google Scholar] [CrossRef]
- Moghaddam, A.; Graeser, V.; Westhauser, F.; Dapunt, U.; Kamradt, T.; Woerner, S.M.; Schmidmaier, G. Patients’ safety: Is there a systemic release of gentamicin by gentamicin-coated tibia nails in clinical use? Ther. Clin. Risk Manag. 2016, 12, 1387. [Google Scholar]
- Khodaei, M.; Valanezhad, A.; Watanabe, I. Controlled gentamicin-strontium release as a dual action bone agent: Combination of the porous titanium scaffold and biodegradable polymers. J. Alloy. Compd. 2017, 720, 22–28. [Google Scholar] [CrossRef]
- Neut, D.; Dijkstra, R.J.; Thompson, J.I.; van der Mei, H.C.; Busscher, H.J. Antibacterial efficacy of a new gentamicin-coating for cementless prostheses compared to gentamicin-loaded bone cement. J. Orthop. Res. 2011, 29, 1654–1661. [Google Scholar] [CrossRef]
- Raschke, M.; Vordemvenne, T.; Fuchs, T. Limb salvage or amputation? The use of a gentamicin coated nail in a severe, grade IIIc tibia fracture. Eur. J. Trauma Emerg. Surg. 2010, 36, 605–608. [Google Scholar] [CrossRef] [PubMed]
- Lucke, M.; Schmidmaier, G.; Sadoni, S.; Wildemann, B.; Schiller, R.; Haas, N.; Raschke, M. Gentamicin coating of metallic implants reduces implant-related osteomyelitis in rats. Bone 2003, 32, 521–531. [Google Scholar] [CrossRef]
- Gollwitzer, H.; Ibrahim, K.; Meyer, H.; Mittelmeier, W.; Busch, R.; Stemberger, A. Antibacterial poly(D,L-lactic acid) coating of medical implants using a biodegradable drug delivery technology. J. Antimicrob. Chemother. 2003, 51, 585–591. [Google Scholar] [CrossRef]
- McMillan, D.J.; Lutton, C.; Rosenzweig, N.; Sriprakash, K.S.; Goss, B.; Stemberger, M.; Schuetz, M.A.; Steck, R. Prevention of Staphylococcus aureus biofilm formation on metallic surgical implants via controlled release of gentamicin. J. Biomed. Sci. Eng. 2011, 4, 535–542. [Google Scholar] [CrossRef]
- Sharma, P.; Naushin, N.; Rohila, S.; Tiwari, A. Magnesium containing High Entropy Alloys. In Magnesium Alloys Structure and Properties; Tański, T.A., Ed.; IntechOpen: Rijeka, Croatia, 2021; pp. 1–26. [Google Scholar]

| Properties | Natural Bone | Magnesium (Mg) | Ti Alloy | Co–Cr Alloy | Stainless Steel (SS) |
|---|---|---|---|---|---|
| Density (g/cm3) | 1.8–2.1 | 1.74–2.0 | 4.4–4.5 | 8.3–9.2 | 7.9–8.1 |
| Fracture toughness (MPa.m1/2) | 3–6 | 15–40 | 55–115 | N/A | 50–200 |
| Elastic modulus (GPa) | 3–20 | 41–45 | 110–117 | 230 | 189–205 |
| Compressive yield strength (MPa) | 130–180 | 65–100 | 758–1117 | 450–1000 | 170–310 |
| Authors | Material | Process of Coating | Reference |
|---|---|---|---|
| Lakawala et al. | PMMA, PDLLA, gentamicin | Aerosol spray technique | [13] |
| Pan et al. | gentamicin, CaCO3 nanoparticles. | Dip-coating method | [68] |
| Morawska-chochol et al. | PLA, Mg, Tricalcium phosphate (TCP), GS, Carbon fiber (C.F.), Alginate Fibre (Alg) | Injection molding method, etching method | [69] |
| Vester et al. | Gentamicin sulphate, PDLLA, Ethyl acetate solution, | Dip-coating | [70] |
| Metsemakers et al. | Gentamicin coated tibia nail, PDLLA | Dip-coating method | [73] |
| Thonse et al. | Gentamicin, PMMA | Metal molds | [74] |
| Raj et al. | Ti sheet, TiO2-SiO2 ceramic, chitosan-lysine (CS-LY-1,2,3) composite, gentamicin | Anodization method, electrodeposition method | [76] |
| Saravanan et al. | Vancomycin, gentamicin bone cement, K-nail | - | [77] |
| Schmidmaier et al. | PDLLA, Chloroform, growth factors | Cold coating technique | [51] |
| He et al. | Gentamicin, Polyacrylic acid (PAA), NaOH solution | Layer by layer | [78] |
| Bhatia et al. | Bone cement, Vancomycin, Teicoplanin, PLLA (polymer) | Push method through endotracheal tube | [79] |
| Vicenti et al. | Gentamicin coated I.M. tibia nail (ETN PROtect DePuy Synthes), Reaming irrigation aspiration. | Dip-coating method. | [80] |
| Pinto et al. | Gentamicin, Poly (D, L-lactide) | Dip-coating process | [81] |
| Moghaddam et al. | Gentamicin coated ETN, Polylactide acid (PDLLA) | Dip-coating process | [82] |
| Khodaei et al. | Ti powder, NaCl (as a spacer agent), Gelatin and strontium hydroxide mixture, gentamicin, Poly-vinyl alcohol (PVA). | Deposition method | [83] |
| Neut et al. | Ti alloy coupon, GS, polylactic glycolic acid, bone cement with polytetrafluoroethylene (PTFE). | Spraying technique | [84] |
| Raschke et al. | Gentamicin, PLLA Tibia nail (UTN Protect) | Dip-coating method | [85] |
| Lucke et al. | K-wire, PBS solution, PDLLA, GS, Group I—K wire (uncoated+PBS as control), Group II—K wire without coating, Group III—K wire coated with PDLLA, Group IV—K wire coated with PDLLA + 10% GS | - | [86] |
| Gollwitzer et al. | PDLLA, ethyl acetate, gentamicin, teicoplanin, | Dip-coating | [87] |
| McMillan et al. | PDLLA in 3 combinations: 1. gentamicin sulphate(GS), 2. vancomycin sulphate (VS), 3. Gentamicin-palmitate (GP) | Dip-coating | [88] |
Publisher’s Note: MDPI stays neutral with regard to jurisdictional claims in published maps and institutional affiliations. |
© 2021 by the authors. Licensee MDPI, Basel, Switzerland. This article is an open access article distributed under the terms and conditions of the Creative Commons Attribution (CC BY) license (https://creativecommons.org/licenses/by/4.0/).
Share and Cite
Tiwari, A.; Sharma, P.; Vishwamitra, B.; Singh, G. Review on Surface Treatment for Implant Infection via Gentamicin and Antibiotic Releasing Coatings. Coatings 2021, 11, 1006. https://doi.org/10.3390/coatings11081006
Tiwari A, Sharma P, Vishwamitra B, Singh G. Review on Surface Treatment for Implant Infection via Gentamicin and Antibiotic Releasing Coatings. Coatings. 2021; 11(8):1006. https://doi.org/10.3390/coatings11081006
Chicago/Turabian StyleTiwari, Abhishek, Prince Sharma, Bhagyashree Vishwamitra, and Gaurav Singh. 2021. "Review on Surface Treatment for Implant Infection via Gentamicin and Antibiotic Releasing Coatings" Coatings 11, no. 8: 1006. https://doi.org/10.3390/coatings11081006
APA StyleTiwari, A., Sharma, P., Vishwamitra, B., & Singh, G. (2021). Review on Surface Treatment for Implant Infection via Gentamicin and Antibiotic Releasing Coatings. Coatings, 11(8), 1006. https://doi.org/10.3390/coatings11081006









